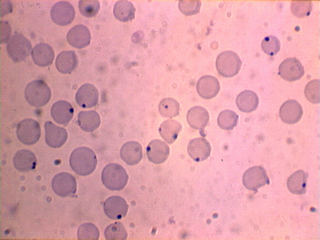

ALGEMENE SIEKTES IN ONS OMGEWING
Dr W J Grobler BVSc.
Die volgende is kort opsommings van die simptome, behandeling, nadoodse tekens en voorkoming van sommige van die belangrikste siektes van beeste in die Rustenburgomgewing. Die skrywer aanvaar geen aanspreeklikheid ten opsigte van die verkeerde diagnose of behandeling van enige dier wat direk of indirek voortspruit uit die lees van hierdie inligting nie. Die onus rus op die boer om met 'n veearts te skakel vir 'n behoorlike diagnose. Indien u meer inligting benodig, skakel gerus u naaste veearts of aan die skrywer.
INHOUDSOPGAWE
| BOSLUIS-OORGEDRAAGDE SIEKTES | VOEDINGVERWANTE SIEKTES |
| Hartwater | Proteïen- en energietekort |
| Rooiwater | Asidose (Suurpens) |
| Bosluisgalsiekte (Anaplasmose) | Rumenstase (Stopgalsiekte) |
| Sweetsiekte | Opblaas |
| VIRUSSIEKTES | Oorvoeding |
| Knopvelsiekte | VERGIFTIGING |
| Drie-dae-stywesiekte | Gifblaar |
| IBR | Tulp |
| BVD (Mukosasiekte) | Lantana |
| BAKTERIESE SIEKTES | Ureum |
| Sponssiekte | Blousuur |
| Lamsiekte | BYLAE |
| Miltsiekte | Lewerondersteuning |
| Paratifus | Antibiotika |
| Brucellose (Besmetlike Misgeboorte) | |
| Leptospirose | |
| Pasteurellose | |
| E. coli |
A. BOSLUIS-OORGEDRAAGDE SIEKTES
1. Hartwater
Seker die belangrikste siekte van herkouers in die gebied. Dit is van die uiterste belang dat alle veeboere hier hulle moet vergewis van die behandeling en voorkoming van die siekte. Oorgedra deur die Bontbosluis. Vir 'n meer volledige bespreking verwys na hierdie artikel.
Simptome
Baie hoë koors, diere trap hoog met die voorpote, oë knip vinnig as op die voorkop getik word, klein bloedinkies op die oogslymvliese, hardloopbewegings as die dier eers lê, wit skuim kom by neusgate uit, soms diaree.
Behandeling
Tetrasikliene (middels met agtervoegsel -mycin), Doksisiklien (Doxymycin). Koorswerende middels.
Nadoodse ondersoek

Wisselende hoeveelhede helder vloeistof word gevind in die hartsak, borsholte, buikholte en longe soos op die foto hiernaas te sien. (Hou die muis oor die verskillende areas om 'n beskrywing van die dele van die liggaam te sien.)
Soms word 'n jellie-agtige stof in die vloeistof gevind. Die groot hoeveelhede vog in die longe (longedeem) lei tot die vorming van wit skuim soos die dier asemhaal. Hierdie skuim word dikwels by die neusopeninge gesien in diere wat terminaal siek is.
Voorkoming
Diere in hartwatergebied moet nie vir lang tye heeltemal vry van bosluise wees nie; dit geld veral kalwers jonger as drie weke. Dien hartwaterbloed toe as die bosluislading laag is, bv. in winterkalwers. Diere ouer as drie weke wat bloed ontvang moet noukeurig dopgehou word en met die eerste tekens van koors behandel word met die middels hierbo genoem. Dragtige diere moet veral baie goed dopgehou word, aangesien die koorsreaksie aborsie kan veroorsaak.
2. Rooiwater

Simptome
Hoë koors, rooierige of bruin uriene, slymvliese bleek (soms geel), vinnige vlak asemhaling, mis pap, dikwels baie geel. Daar is 'n tipe rooiwaterorganisme wat senuweesimptome baie soos die van hartwater veroorsaak. Dit word Europese rooiwater genoem en die organismes word dan in rooibloedselle in die brein gesien. (Die organismes is die donker spikkels op die foto regs). Die siekte word deur die bloubosluis oorgedra.
Behandeling
Berenil, Dimisol, Reverin of Forray 65, vit B-kompleks, lewerondersteuningsmiddels.
Nadoodse ondersoek
Bloed baie waterig, uriene donker, milt vergroot. Organismes kan in 'n bloedsmeer gesien word. In die geval van Europese rooiwater vertoon die brein dikwels donkerpienk van kleur soos hieronder gesien.

Voorkoming
Diere vanuit areas waar rooiwater nie voorkom nie kan geënt word. Daar moet gewaak word daarteen om diere in gebiede waar die siekte wel voorkom, nie te skoon van bosluise te hou nie. Diere kan hul weerstand binne 'n paar maande verloor. Kalwers het 'n natuurlike weerstand tot ongeveer ses maande oud en raak meestal immuun in gebiede waar die siekte voorkom, maar in uitsonderlike gevalle kan jong kalwers tog siek word.
3. Galsiekte
Simptome
Wisselende koors, bleek/geel slymvliese, droë mis, uriene baie geel. Die bloubosluis dra beide soorte galkoorsorganismes oor.
Behandeling
Tetrasikliene (dubbel dosis), Doksisiklien, Forray 65. Lewerondersteuning. Rumenondersteuning
Nadoodse ondersoek
Bloed baie waterig, vliese en slymvliese geel, lewer geel (selfs oranje), pensmis baie droog. Die organismes kan in 'n bloedsmeer gesien word soos op die foto regs. Die organismes is die klein donkerblou kolletjies op die rooibloedselle.
Voorkoming
Dieselfde as rooiwater.
4. Sweetsiekte
Kom gewoonlik in jong kalwers voor en word deur die Bontpootbosluis veroorsaak.
Simptome
Vel nat en hare val maklik uit soos hieronder links gesien. Speekselvloei, diere kreun baie (buikpyn). Die siekte word gekenmerk deur ernstige inflammasie van die vel, lugweë en dermkanaal. Hieronder aan die regterkant is 'n voorbeeld van erge inflammasie van die slukderm. Dit is duidelik dat so 'n dier geweldig pyn verduur en daarom nie wil drink nie.


Behandeling
Vloeistowwe (mondelings of deur drup), antibiotika, koorswerende middels. Verwyder alle bontpootbosluise met die hand. (Kyk ook in die stertkwas) Kalwers met sweetsiekte ontwater maklik aangesien liggaamsvloeistowwe deur die ontsteekte vel ontsnap en hulle a.g.v. ontsteking van die bekslymvlies onwillig is om te drink.
B. VIRUSSIEKTES
1. Knopvelsiekte

Simptome
Word vermoedelik deur bytende insekte oorgedra, maar die speeksel van besmette diere is ook aansteeklik en kan met drinkwater oorgedra word. Aanvanklik wys diere speekselvloei, neusafskeiding en mankheid wat nie juis die eienaar opval nie. 'n Week later begin opvallende knoppe egter regoor die lyf uitslaan. Die knoppe wissel van 1 to 4 cm in deursnit en kan of vanself verdwyn of die vel sterf af en laat redelike diep sere wat 'n geruime tyd neem om te genees. In 1997 is letsels selfs in kalwers van 10 dae oud gesien! In erge gevalle word moeilike asemhaling ondervind a.g.v. letsels in die lugpyp. Letsels kan ook in die dermkanaal ontstaan.
Behandeling
Antibiotika teen sekondêre infeksie van die vel. Indien die dooie vel begin losgaan, moet gewaak word teen maaiers. Diere wat baie moeilik asemhaal staan ‘n goeie kans om te vrek.
Voorkoming
Kalwers word op ses maande oud die eerste keer geënt. Die inenting moet jaarliks herhaal word.
2. Drie-dae-stywesiekte
Simptome
Die virus word deur bytende insekte oorgedra. Alle ouderdomme diere is ewe vatbaar, maar swaar bulle en koeie wys die duidelikste simptome. Diere lê baie, bewe as hulle staan en loop met stywe ledemate. Dikwels is daar helder neusafskeiding en speekselvloei. Die mis is dikwels slymerig en bevat soms bloed. In baie swaar bulle kan die simptome skielik en baie dramaties wees. Asemhaling is vinnig en in uitsonderlike gevalle kan daar sponserige swelsels oor die bors verskyn wat onderskei moet word van sponssiekteletsels. Koeie droog dikwels op.
Behandeling
Antibiotika, pynstillers en algemene verpleging van diere wat lê.
Nadoodse ondersoek
 Tekens van ontsteking in gewrigte en spiere, emfiseem van die longe. Op die foto links is 'n geval met erge aansameling van inflammatoriese afskeiding om die spierpese (senings). In die
gevalle waar swelsels onder die vel voorkom is die blasies net onder die vel en die
lug in die blasies is helder. (Sponssiekte — blasies in die spier met baie stink,
bloederige vloeistof)
Tekens van ontsteking in gewrigte en spiere, emfiseem van die longe. Op die foto links is 'n geval met erge aansameling van inflammatoriese afskeiding om die spierpese (senings). In die
gevalle waar swelsels onder die vel voorkom is die blasies net onder die vel en die
lug in die blasies is helder. (Sponssiekte — blasies in die spier met baie stink,
bloederige vloeistof)
Voorkoming
Ent bulle en melkkoeie jaarliks.
3. IBR (Beesverkoue)
Simptome
Aanvanklik helder neusafskeiding, oë traan. Soms diaree in jong kalwers. Hierdie virus kan aborsies veroorsaak, gewoonlik 'n ruk na die asemhalingsimptome, maar meestal wys koeie geen simptome nie. Die infeksie kan die dier meer vatbaar maak vir Pasteurellose.
Behandeling
Tetrasikliene, Sulfamiddels, nuwer antibiotika.
Ent kalwers vier weke voor speen. IBR word gewoonlik gekombineer met die virusse van BVD (Beesvirusdiaree/Slymvliessiekte), Parainfluenza 3 en Beessinsitiaalvirus, almal virusse wat die asemhalingsweë aantas. Let net op — die entstowwe wat lewende IBR-virus bevat moet nie in dragtige koeie gebruik word nie!
4. Slymvliessiekte(Mucosal disease)
Simptome
Veroorsaak erge diaree en letsels in die bek en neusslymvlies. Gewoonlik word klein seertjies in die bek en neus aangetref. Hierdie sere kan sekondêr besmet word en baie ongemaklik vir die dier wees. Aborsies en misvorming van kalwers kom gereeld voor met die siekte. Die siekte kom nog nie wyd in SA voor nie, maar kan vinnig versprei in 'n vatbare bevolking. Meer inligting kan hier verkry word.
Behandeling
Antibiotika om sekondêre infeksie te beperk.
Voorkoming
Ent diere jaarliks met entstofkombinasies wat hierdie virus bevat, veral voor speen. Die virus word gewoonlik met IBR-, Parainfluenza- en Sinsitiaalvirus gekombineer.
C. BAKTERIESE SIEKTES
1. Sponssiekte
Slegs diere jonger as drie jaar is vatbaar vir dié ernstige siekte wat meestal diere in goeie kondisie aantas. Dikwels word meer as een dier siek en diere word baie selde deurgehaal.
Diere dikwels dood aangetref. Siek diere wys erge mankheid met erge swelsel van veral een agterkwart, maar soms word die skouer en selde die hart of diafragma aangetas. Die siekte kan selfs in die niere ontstaan!
Behandeling
Hoë dosisse penisillien kan probeer word in vroeë gevalle, maar is van weinig waarde aangesien die bakterieë baie skade aan die weefsels aanrig.
Nadoodse ondersoek
 Uitwendig kom die karkas baie geswel voor aan die een kant. Met insnyding
van die aangetaste dele is daar sponserigheid van die spiere met 'n galsterige
reuk soos bottersuur en donker verkleuring van die spiere (duidelik te sien in die foto links). Letsels kan ook in
die ingewande voorkom, veral in die hart en diafragma. Sponssiekteletsels
moet egter onderskei word van verrotting (die hele karkas aangetas) en emfiseem
(blasies helder, tussen spiere, geen vloeistof) soos aangetref by Drie-dae-stywesiekte en beserings van die lugpyp. (bv. as bulle baklei het)
Uitwendig kom die karkas baie geswel voor aan die een kant. Met insnyding
van die aangetaste dele is daar sponserigheid van die spiere met 'n galsterige
reuk soos bottersuur en donker verkleuring van die spiere (duidelik te sien in die foto links). Letsels kan ook in
die ingewande voorkom, veral in die hart en diafragma. Sponssiekteletsels
moet egter onderskei word van verrotting (die hele karkas aangetas) en emfiseem
(blasies helder, tussen spiere, geen vloeistof) soos aangetref by Drie-dae-stywesiekte en beserings van die lugpyp. (bv. as bulle baklei het)
Voorkoming
Ent alle diere vanaf 4 - 5 maande twee keer en dan jaarliks tot drie jaar oud. Indien sponssiekte voorkom ten spyte van inenting moet monsters vir ontleding geneem word. Daar is verskeie organismes wat sponssiekte-agtige letsels kan verwek, maar waarteen die gewone entstof nie beskerm nie. Daar is egter kommersiële entstowwe teen dié organismes beskikbaar.
2. Lamsiekte
Word veroorsaak deur 'n baie sterk gifstof wat in verrottende karkasse gevorm word deur die lamsiektekiem. Beeste wat aan 'n fosfaattekort ly is geneig om bene te eet ten einde hul fosfaathonger te stil en kry so van die gifstof in. Die gifstof kan ook in hoendermis van braaikuikens afkomstig voorkom. In dié geval groei die organismes in karkasse van dooie kuikens.
Simptome
Die gifstof veroorsaak verlamming van al die spiere in die liggaam. In 'n tipiese geval lê die dier op die bors met die kop na die sy gedraai. Die stert is heeltemal pap en die tong kan sonder veel moeite uitgetrek word waar dit bly hang. Die dier kan dit nie weer teruggetrek nie.
Nadoodse ondersoek
Daar is geen spesifieke nadoodse letsels met lamsiekte nie. Dikwels word bene in die ruitjiespens gevind.
Voorkoming
Ent alle diere jaarliks, veral as hoendermis gevoer word. Fosfaat behoort regdeur die jaar in 'n lek voorsien te word. Sover moontlik moet karkasse van wild, selfs hase en skilpaaie verbrand word ten einde die bron van groei vir die organismes te verwyder.
3. Miltsiekte
Simptome
Diere word gewoonlik dood aangetref met 'n swart, teeragtige uitloopsel by die liggaamsopeninge soos op die foto links onder. Indien Miltsiekte enigsins vermoed word mag die karkas onder geen omstandighede oopgemaak word nie en moet die Staatsveearts so gou moontlik in kennis gestel word. Die karkas bevat miljoene der miljoene organismes (sien regs onder) wat spore vorm as hul aan lug blootgestel word. Hierdie spore kan vir veertig jaar of meer in die omgewing oorleef!


Voorkoming
Volgens wet moet alle diere jaarliks teen dié siekte geënt word.
4. Kalwerparatifus
Simptome
Ernstige diarree in kalwers gewoonlik jonger as drie weke. Die maagwerk is dikwels bloederig en diere kan binne 24 uur vrek a.g.v. ontwatering. Die organismes kan ook regdeur die liggaam versprei en bloedvergiftiging veroorsaak. In minder ernstige gevalle kan dit lei tot gewrigsontsteking nadat die diarree reeds opgeklaar het.
Behandeling
Antibiotika, veral Sulfamiddels en nuwer antibiotika (raadpleeg u veearts). Weerhou melk totdat die diarree opgeklaar het en vervang dit met elektroliete opgelos in louwarm water. In baie ernstige gevalle mag dit lonend wees om waardevolle kalwers drupvloeistof binne-aars te gee. Kaolien of geaktiveerde houtskool kan gegee word om die derminhoud te bind en gifstowwe te absorbeer.
Voorkoming
Laat koeie kalf waar daar minder bakterieë teenwoordig is, m.a.w. in die veld. Maak seker dat kalwers ten minste een liter bies inkry binne ses ure na kalwing. Dit is 'n goeie idee om so twee liter bies in die vrieskas te bêre vir noodgevalle. (Die ou boereraat van eiergeel in melk is ongelukkig nie 'n plaasvervanger vir bies nie, maar daar is deesdae 'n kunsmatige bies, Bioglobin, wat as plaasvervanger vir bies gegee kan word) Weekoue kalwers kan met die lewende entstof geënt word, sommer saam met die toediening van hartwaterbloed.
5. Besmetlike misgeboorte (Brusellose)
Hierdie is 'n hoogs aansteeklike siekte wat die mens ook baie siek kan maak. Die siekte word nie deur dekking oorgedra nie, maar miljoene organismes word aangetref in die uitgewerpte fetus, nageboorte en baarmoederafskeidings vanwaar die weiding en die omgewing besmet word. As 'n ander dier die organismes inkry vestig hulle in die uier, baarmoeder en limfknope.
Simptome

Indien die siekte vir die eerste keer in 'n vatbare kudde voorkom, aborteer verskeie
van die diere en die nageboortes kom nie normaal af nie. Na die aanvanklike
vlaag aborsies kom daar net af en toe aborsies voor, maar die nageboortes wat
vassit bly 'n algemene probleem. Soos links gesien kom daar dikwels ontsteking van die nageboorte voor wat die rede vir die aborsies en vassit van nageboortes is.
Voorkoming
Ent verse tussen 6 en 8 maande met die S19-entstof van Onderstepoort. Ouer diere mag nie met hierdie entstof geënt word nie. Opvolginentings met die RB51 entstof op jaaroud en voor eerste dekking sal sorg dat die kudde 'n goeie immuniteit opbou. Laat die kudde gereeld toets. Indien aborsies voorkom moet die fetus begrawe of verbrand word en koeie waarvan die nageboorte vassit moet van die kudde geïsoleer word. Indien die nageboorte verwyder word, werk baie versigtig om uself teen die siekte te beskerm. Nageboortes moet diep begrawe of verbrand word om verspreiding van die bakteriëe deur vlieë te voorkom. Enige diere wat ingekoop word moet eers negatief getoets word voordat hulle in kontak met die res van die diere gebring word.
Brusellose is nie die enigste oorsaak van aborsies in beeste nie. Daar is 'n hele aantal moontlike oorsake en dit is ongelukkig nie altyd moontlik om die oorsaak vas te stel nie. Indien aborsies voorkom moet serum van die betrokke koeie geneem word om te toets vir Brusellose en Leptospirose. Indien moontlik kan die fetus en nageboorte op ys ingestuur word na 'n laboratorium vir ontleding. As die fetus egter reeds ontbind het is die kanse op 'n antwoord baie skraal.
6. Leptospirose
Hierdie organismes oorleef makliker in 'n nat omgewing soos in vleie of waar diere onder swak toestande aangehou word. Rotte en muise kan ook as draers van die organismes optree.
Simptome
Hoë koors, geelsug, bloederige uriene en aborsies. Die siekte kan maklik met Rooiwater verwar word. Nadat diere herstel het word die organismes gewoonlik vir maande na die tyd in die uriene uitgeskei.

Leptospirose van die nier. (Die dun swart strepies is die bakterieë).
Behandeling
Tetrasikliene, Streptomisien.
Voorkoming
Plaagbeheer, herstel lekkende drinkbakke.
7. Pasteurellose
Kom veral in periodes van abnormale stres voor bv. na speen, vervoer oor lang afstande, stowwerige of winderige toestande en wanneer groot groepe vreemde diere bymekaargegooi word. (voerkrale)
Simptome
Hoë koors, baie lusteloos, haal vinnig of geforseerd asem, neusafskeiding, hoes soms. Diere wat tot 'n mindere mate aangetas is doen swak en verloor baie gewig in 'n kort tyd. In ernstige gevalle kan diere binne etlike ure vrek.
Behandeling
Antibiotika — Tetrasikliene, Sulfamiddels en van die nuwe antibiotika waarvan sommige spesiaal vir die behandeling van pasteurellose ontwikkel is. (kontak gerus u veearts vir meer besonderhede). Pynstillers. Vit C. Ondersteuning van die rumen in chroniese gevalle.
Nadoodse ondersoek
Longe donker van kleur, redelik verhard. Vloeistof in die borsholte, dikwels met strooikleurige stolsels daarbinne. In lankstaande gevalle kleef die longe aan die borswand vas. Absesse kom soms in die longe voor, veral as die dier vir 'n geruime tyd siek was. In ernstige gevalle kan 'n letsel so groot soos 'n vuis die dood van die dier veroorsaak!
Voorkoming
Aangesien verskeie virussiektes die dier meer vatbaar maak vir Pasteurellose kan dit help om teen dié siektes te ent voordat kalwers gespeen word of na voer- krale vervoer word. Ent dus met die kombinasie-entstowwe wat IBR-, BVD-, Parainfluenza- en Beessinsitiaalvirus bevat ten minste vier weke voor speen. Ent alle diere jaarliks met Pastvac of die nuwe Onderstepoortentstof. (Leukopast of Leukopast 3)
8. E. coli
Dié organisme kom in mis voor en is in hoë konsentrasies teenwoordig waar diere saamdrom bv. in krale en by drinkplekke. Die organisme word deur die bek ingeneem as die kalf suip of kan die liggaam deur die naelstring binnedring.
Simptome
Diarree in jong kalwers (gewoonlik wit van kleur). Naelstringontsteking, bloedvergiftiging en gewrigsontsteking. Die siekte is gewoonlik dodelik in kalwers wat nie bies ingekry het nie.
Behandeling
Dieselfde beginsels geld as wat vir Paratifus bespreek is. Hierdie organismes toon dikwels weerstand teen die algemene antibiotika en dit is gewoonlik beter om van die nuwere antibiotika soos die kwinoloonderivate gebruik te maak.
Voorkoming
Verseker biesinname. Ent koeie vier weke voor kalwing met E. coli-entstof. Daar is ook entstowwe beskikbaar wat E. coli kombineer met ander organismes wat diaree in kalwers veroorsaak. Ontsmet die naelstring van pasgebore kalwers met jodium en gee spesiale aandag aan higiëne waar kalwers intensief grootgemaak word.
D. VOEDINGSPROBLEME
1. Proteïen- en energietekort
In die wintermaande neem die voedingswaarde van die weiding dramaties af. Nie net is die voginhoud van veldgras baie minder nie; ook die proteïen- en energie-inhoud is verminder. Dit lei daartoe dat diere heelwat meer materiaal moet inneem om in hul behoeftes te voorsien. In swaar dragtige koeie is daar egter nie genoeg spasie vir al die kos nie aangesien die dragtige baarmoeder baie ruimte opneem. Hierdie diere neem dus minder in as wat die groeiende kalfie nodig het en so moet die koei se liggaamsreserwes afgebreek word om in die kalf se behoeftes te voorsien. Die uiteinde is dat die koei vermaer en in erge gevalle selfs haar eie spiere afbreek en so al hoe swakker word. Dikwels kan die erg verswakte spiere nie die swaarderwordende baarmoeder dra nie en die koei gaan lê om in meeste gevalle nie weer op te staan nie.
Voorkoming
Dragtige diere moet goed dopgehou word in die wintermaande. Indien hul kondisie drasties afneem moet plan gemaak word om byvoeding te gee in die vorm van goeie kwaliteit hooi en/of konsentraatvoeding. In alle gevalle behoort 'n winterlek voorsien te word om diere te help om die swakker kwaliteit veld beter te benut. Kalwers behoort vroeër gespeen te word as die koeie se kondisie te veel verswak.
2. Suurpens
Die grootpens (rumen) van herkouers is 'n spesiale gistingstenk waarin miljoene mikroskopiese organismes en bakterieë leef. Hierdie organismes is verantwoordelik vir die vertering van sellulose wat die hoofbestanddeel van plantselwande is. Sonder hierdie klein organismes kan 'n bees nie plantmateriaal verteer nie en dus nie aan die lewe bly nie. Die omstandighede in die grootpens moet egter redelik konstant gehou word anders sterf die organismes af. Indien die dier te veel koolhidrate (stysel) inkry, word melksuur gevorm wat die inhoud van die grootpens suur maak. Die meeste organismes sterf af in hierdie suur omgewing terwyl melksuurbakterieë goed oorleef en nog meer suur vorm wat uiteindelik die dier se dood veroorsaak.
Simptome
Diaree wat suur ruik, opblaas, diere lê dikwels.
Behandeling
Gee dadelik 'n teensuurmiddel in. Meng 'n goeie dosis Penisillien met die teensuur. Spuit vit B-kompleks vir paar dae. In erge gevalle kan geaktiveerde houtskool ook ingegee word, maar nie saam met die teensuur nie.
Nadoodse ondersoek
Grootpens gevul met groot hoeveelhede waterige inhoud. Inhoud ruik suur en toon dikwels oormaat mielies.
Voorkoming
Beeste moet geleidelik blootgestel word aan voer wat groot hoeveelhede stysel bevat (mielies, koring, sorghum, brood of gedroogde pap). Sluit konsentraat goed toe sodat diere nie per ongeluk toegang daartoe kry nie. Wees baie versigtig as diere skougereedgemaak word.
3. Stopgalsiekte
Die organismes in die grootpens teer self op die plantmateriaal wat die bees eet en bly so aan die lewe. Die grootpens meng sy inhoud elke paar minute om te verseker dat die gras en vloeistof goed gemeng bly sodat vertering kan plaasvind. Indien die bees ophou vreet of koors ontwikkel wat die grootpensbeweging onderdruk, meng die inhoud nie behoorlik nie en word vertering vertraag. Dit lei tot 'n daling in die suurheid van die grootpens en afsterwing van die organismes.
Hierdie daling in getalle van die grootpensorganismes lei tot verdere daling in die suurheid en verdere afsterwing van die organismes. Uiteindelik is daar geen aktiwiteit van die grootpens nie en word daarna verwys as rumenstase of stopgalsiekte. Die dier sal sterf indien die grootpens nie aan die gang gehelp word nie.
Simptome
Dikwels is die tekens van die oorspronklike siekte reeds verby. Die dier wil glad nie vreet of herkou nie. Mis droog, selfs harde balle wat met 'n taai slym bedek is.
Behandeling
Gee een bottel asyn, een koppie bruinsuiker, een koppie brouersgis met water gemeng baie versigtig in. In plaas van dié mengsel kan galpoeier of poeiers soos Rumagest Forte of Kyrogest Forte met water gegee word. Sorghumbier kan ook van waarde wees. In erge gevalle is die enigste raad om vars pensmiswater in te gee. Dit is belangrik dat die pensmiswater warm gehou moet word anders sterf die organismes af en is dit nie van nut nie.
Voorkoming
Behandel siek diere so gou as moontlik. As die dier nie binne 24 uur begin vreet nie gee aandag aan die grootpens. Sorg vir voldoende en tydige waterpunte veral in die winter. Voorsien diere van winterlek so gou as wat die veld begin verbruin. Verander geleidelik van voeding sodat diere nie heeltemal ophou vreet nie.
4. Opblaas
Daar is twee soorte opblaas: Vry gasopblaas en skuimopblaas.
a) Vry gasopblaas
Daar word normaalweg groot hoeveelhede gas in die grootpens gevorm deur die organismes wat vertering bewerkstellig. Die dier raak ontslae van die gas deur winde op te breek. As daar 'n vreemde voorwerp in die slukderm vassit of as die grootpens nie kan saamtrek a.g.v. beskadiging van sy senuwees samel die gas aan in die grootpens. Hoe meer gas aansamel hoe minder waarskynlik is dit dat die gas wel sal ontsnap. Die geweldige groot grootpens druk op die diafragma en die borsholte en die dier versmoor.
Behandeling
In baie vroeë gevalle help dit om die dier skuins te laat staan met die voorlyf hoër as die agterlyf. In erger gevalle moet die gas uitgelaat word deur 'n stywe pyp by die dier se slukderm af te druk. Die gebruik van 'n trokar moet beperk word tot baie ernstige gevalle waar die dier besig is om te sterf. Indien die oorsaak 'n senuweebesering is sal die opblaas waarskynlik herhaal en in chroniese gevalle is die enigste oplossing om die dier te laat slag.
Voorkoming
Sorg dat diere wat lê op die bors lê en nie op die sy nie.
b) Skuimopblaas
Gewoonlik samel die gas wat in die grootpens gevorm word op een plek aan heel bo in die grootpens. Vandaar beweeg die gas deur die slukderm na buite. In sommige gevalle word die gas vasgevang in die grootpensvloeistof en word skuim gevorm. Die teenwoordigheid van skuim verhoed die normale opbreek van die gas en dit samel dus oormatig aan. Oorsake hiervan is hoë konsentraatvoeding en sekere plante bv. lusern.
Behandeling
Olie, poeierseep of middels soos Bloatguard word in die grootpens geplaas, verkieslik met 'n maagbuis. Nadat die skuim opgebreek is sal die vry gas deur die pyp ontsnap.
Voorkoming
Wees versigtig met die voer van hoë konsentraatrantsoene. Dit is dikwels die moeite werd om teensuurmiddels saam met die rantsoen te gee. Moenie honger diere vrye toegang tot lusernlande gee nie. Daar is middels wat as 'n topdressing gegee kan word om weidings te beveilig.
5. Oorvoeding
Nie algemeen nie, maar kan 'n probleem by skoudiere wees. By vroulike diere lei 'n oormaat vet tot verlaagde vrugbaarheid en in erge gevalle tot moeilike kalwings. In manlike diere kan oorgewig lei tot oormatige spanning op die gewrigte en dit kan gewrigsontsteking veroorsaak. Op die kort termyn kan dit ook lei tot suurpens en opblaas soos alreeds bespreek. Chroniese suurpens lei tot lewerabsessasie en kan vit B1-tekort veroorsaak wat simptome soortgelyk aan hartwater gee.
E. VERGIFTIGINGS
1. Gifblaar
 Die meeste probleme kom voor in September wanneer die jong plantjies soos hier langsaan gesien, uitkom.
In die herfs kan daar ook vergiftiging plaasvind, veral in diere wat nie gewoond
is aan die plant nie (kalwers en vreemde diere).
Die meeste probleme kom voor in September wanneer die jong plantjies soos hier langsaan gesien, uitkom.
In die herfs kan daar ook vergiftiging plaasvind, veral in diere wat nie gewoond
is aan die plant nie (kalwers en vreemde diere).
Simptome
Skielike vrekte veral nadat diere water gedrink het of as kalwers gesuip het. Soms word 'n aangetaste dier gesien wat baie bewe en dronkerig voorkom.
Behandeling
Geen. As dit vermoed word moet diere nie aangejaag word of hanteer word nie. Hou diere weg van water vir ongeveer 48 uur. Pasop egter vir ontwatering in die somermaande.
Voorkoming
Chemiese beheer van die plante. Kamp areas af en vermy dié kampe in gevaar- periodes voordat gras begin groei.
2. Tulp
 Dié plant het 'n ondergrondse bol wat baie gehard is. Die blare is onopvallend
en 'n geel (sien regs) of ligpers Iristipe blom word gedra. Vergiftiging kom gewoonlik in die
lente voor wanneer die jong blare begin uitloop.
Dié plant het 'n ondergrondse bol wat baie gehard is. Die blare is onopvallend
en 'n geel (sien regs) of ligpers Iristipe blom word gedra. Vergiftiging kom gewoonlik in die
lente voor wanneer die jong blare begin uitloop.
Simptome
Diaree, dronkerigheid, bewe baie, val maklik om. Die simptome kan maklik met dié van hartwater verwar word. In dié geval is daar egter geen koors nie.
Behandeling
Gee geaktiveerde houtskool of PPR-poeier gemeng met water in.
Voorkoming
Chemiese beheer van plante en vermy besmette areas in gevaartye.
3. Lantana
 Hierdie plant is 'n algemene indringerplant en is 'n verklaarde onkruid. Die blare
en stingels is redelik hard, maar sommige diere vreet dit geredelik. Die gifstof
tas die lewer aan en moet oor 'n lang periode ingeneem word voordat simptome
verskyn.
Hierdie plant is 'n algemene indringerplant en is 'n verklaarde onkruid. Die blare
en stingels is redelik hard, maar sommige diere vreet dit geredelik. Die gifstof
tas die lewer aan en moet oor 'n lang periode ingeneem word voordat simptome
verskyn.
Simptome
Geelsug, afskilfering van die neus, wit dele van die vel baie rooi (sensitief vir die son), in sommige gevalle bloedings.
Behandeling
Hou dier in die koelte, gee lewerondersteuningsmiddels en pynstillers. Herstel vind oor 'n lang periode plaas.
Nadoodse ondersoek
Alle weefsels geel verkleur deur geelsug, bloedings (kan baie erg wees), wit dele van die vel rooi en ontsteek, galblaas soms baie groot en gevul met waterige wit gal.
Voorkoming
Roei die plant uit.
4. Ureum
Ureum word in winterlekke ingesluit om as voedsel te dien vir die mikroskopiese organismes wat dan deur die bees gebruik word as proteïenbron. In oormaat word die ureum afgebreek na ammoniak wat die dier vergiftig.
Simptome
Erge opblaas, senuweesimptome.
Behandeling
Dien sowat 4 liter asyn versigtig toe.
Nadoodse ondersoek
Opblaas, grootpensinhoud alkalies, water op longe en skuim in die lugpyp.
Voorkoming
Maak diere geleidelik gewoond aan winterlek. Indien lek self gemeng word moet seker gemaak word dat daar nie ureumklonte in die mengsel is nie en dat die ureum deeglik ingemeng word. Winterlek moet verkieslik onder dak gehou word sodat dit nie nat word nie.
5. Blousuur
Blousuur (sianied) kom in baie plante voor waarin dit aan sekere suikers gebind is. Die blousuur word vrygestel as die plante beskadig word deur ryp, vertrapping of verwelking. Die gifstof meng in met suurstofverbruik in selle en is in meeste gevalle dodelik.
Simptome
Skielike vrekte kort na inname van plante met hoë blousuurinhoud. Aangetaste diere steier rond, bewe baie, kom geweldig onrustig voor en vrek binne oomblikke. Aangetaste diere blaas maklik op.
Behandeling
In ernstige gevalle word 'n mengsel van Natriumnitriet en Natriumtiosulfaat (Hypo) binne-aars toegedien. In minder ernstige gevalle word Hypo mondelings toegedien. Dit kan ook in die water toegedien word waar diere toegang tot gevaarlike weiding gehad het en nog nie simptome wys nie.
Nadoodse ondersoek
Opblaas, amandelreuk in grootpens in vars karkas.
Voorkoming
Vermy wei van gewasse in gevaartye. Voersorghum moet nie bewei word voordat dit ten minste 50 cm hoog is nie. Gevaarlike gewasse moet ook nie bewei word as dit doodgeryp is of verwelk het nie, veral as die beskadiging na 'n periode van vinnige groei plaasgevind het. Blomswael in 'n lek ingesluit teen 5% sal help om vergiftiging te voorkom.
Blousuur kom veral in die volgende plante voor: Graansorghum, Kweek, verskeie Acacia spesies (doringbome) en Gousblomme of Bietou.
BYLAE
LEWERONDERSTEUNING
Die lewer is 'n belangrike orgaan waarvan die funksie deur sommige siektes aangetas word. In alle gevalle waar die lewer betrek is word die volgende algemene riglyne van behandeling gevolg:
Gee middels wat galdrywing stimuleer soos Tioctan Vet en DL- methionien. Wateroplosbare vitamiene veral vit B-kompleks en fosforpreparate moet gegee word om die eetlus aan te wakker. Verseker dat die grootpens nie ophou funksioneer nie.(Sien Stopgalsiekte) Hou diere in die koelte as dit lyk of die vel baie sensitief is vir lig. Voorsien goeie kwaliteit ruvoer. Indien diere baie sensitief is vir lig soos met Lantana-vergiftiging, is dit verkieslik om nie groenvoer te gee nie, behalwe as dit prakties moontlik is om hulle uit die son te hou.
Diere waarvan die lewer ernstig beskadig is moet 'n lang herstelperiode gegun word. In die geval van Bosluisgalsiekte en Lantana-vergiftiging kan dit 'n paar weke neem voordat diere behoorlik herstel het. Dit is ook belangrik dat die geelsug volledig opgeklaar het voordat diere vir slagting gestuur word, aangesien die karkas afgekeur mag word indien dit nie die geval is nie.
ANTIBIOTIKA
Antibiotikum beteken teen lewe. In die natuur word antibiotika deur lewende organismes (gewoonlik swamme) gevorm om kompetisie deur bakterieë uit te skakel. Die mens vervaardig hierdie stowwe kunsmatig om te help om bakterieë wat siekte veroorsaak te dood. Let net op dat antibiotika glad nie effektief is teen virusse nie. Antibiotika het deur die jare al miljoene mens en dierelewens gered, maar die onoordeelkundige gebruik daarvan kan tot probleme lei.
Die onnodige gebruik van antibiotika of onderdosering daarvan kan lei tot weerstand onder bakterieë. Dit beteken dat bakterieë wat vantevore deur 'n sekere antibiotikum gedood is, nou nie meer daardeur beïnvloed word nie. In 'n sekere bevolking bakterieë is daar altyd 'n klein persentasie wat nie deur die antibiotika gedood word nie. Oorgebruik of onderdosering lei daartoe dat hierdie weerstandige bakterieë die kans gegun word om te vermenigvuldig en so al hoe meer te word sonder dat daar kompetisie met vatbare bakterieë is. In mense wat immuunonderdruk is (bv. VIGS-pasiënte en orgaanontvangers) kry hierdie weerstandige bakterieë maklik die oorhand, want die liggaam se eie immuunstelsel is te swak om te help veg teen die bakterieë. Almal wat toegang het tot antibiotika (aptekers, dokters, veeartse en boere) moet oordeelkundig met antibiotika te werk gaan sodat hierdie probleem die hoof gebied kan word.
Die verkeerde gebruik van antibiotika kan ook veroorsaak dat dit op die verbruiker se bord beland. Dit kan baie nadelige gevolge inhou, veral vir persone wat allergies is vir sekere middels. Die blootstel van die bakterieë in ons dermkanaal aan klein hoeveelhede antibiotika in ons kos kan egter ook die voorkoms van weerstand onder bakterieë aanhelp. Dit is dus belangrik dat aandag geskenk word aan die onttrekkingsperiodes van antibiotika-bevattende middels.
Indien u enige navrae het van watter aard ookal — vra raad by die een persoon wat spesiaal opgelei is om u met veeprobleme te help... DIE VEEARTS!
Erkenning vir foto's:
Foto's van gifplante: Vergiftiging van mens en dier in Suid-Afrika Johannes Vahrmeyer
Alle ander foto's: Bristol Image Archives © University of Bristol 2000